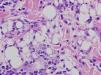

We herein report a patient who came to the hospital because of a polyarticular joint pain, fever and cutaneous lesions. She had silicone implants in her buttocks, a surgery performed 3 years before. We made a biopsy of the skin of the buttocks (facticial panniculitis due to silicone) and of the pretibial surface of the inferior extremities (erythema nodosum). A chest X-ray and a CT scan revealed bilateral hilar lymphadenopathy, and a transbronquial biopsy showed granulomatous inflammation. She had a good response to rest and anti-inflammatory drugs, so the removal of the silicone implants has not been necessary yet.
Se presenta el caso clínico de una paciente que ingresó en nuestro servicio por clínica de poliartralgias, fiebre y lesiones cutáneas que afectaban a la región glútea y pretibial. Refería como antecedente la aplicación de inyecciones de silicona líquida en los glúteos con fines estéticos 3 años antes. Se realizó biopsia cutánea de las lesiones en la región glútea cuyo estudio anatomo-patológico fue compatible con paniculitis facticia por silicona así como de la región pretibial que fueron compatibles con eritema nodoso. La radiografía de tórax y el TAC torácico mostraron adenopatías hiliares bilaterales, y en la biopsia transbronquial se evidenció componente inflamatorio granulomatoso. La evolución fue satisfactoria con reposo y antiinflamatorios no esteroideos, por lo que no fue necesaria la extracción de la silicona.
Prostheses or silicone injections for cosmetic use to enhance or correct volume lead to tissue scarring. Although silicone has been considered an inert material, it is now known to produce local or systemic adverse reactions, with a latent period even lasting decades. Between local reactions it induces factitual panniculitis1 due to foreign body or systemic reactions and some cases of connective tissue disease have been described.2 In recent years several cases of sarcoidosis that occurred after injection of silicone for esthetic purposes in distant localizations3–8 have been described in the literature. Most of these cases required the use of corticosteroids for symptom control, together with the removal of the silicone.
We describe a patient who, after the injection of liquid silicone, presented a local complication (factitious panniculitis) along with systemic complications (Löfgren syndrome).
Case ReportThe patient is a 44-year-old woman without medical or surgical history of interest, a native of Colombia, a resident in Spain for 10 years. She had a history of liquid silicone injections in the buttocks 3 years earlier while in Colombia.
She was by rheumatology due to joint pain in knees with posterior involvement of the ankles, elbows and wrists of one week of progression, along with a raised, erythematous, nonpruritic, painful skin lesions on both buttocks (Fig. 1) and fever (37.6°C). The patient did not present general manifestations or morning stiffness, no manifestations suggestive of infection and denied foreign travel in recent months, as well as drug and alcohol consumption.
Physical examination found her hemodynamically stable, afebrile and in good overall condition. Musculoskeletal examination found a local temperature increase on both knees, with pain on flexion and extension, without erythema or effusion, along with swelling and increased local temperature in both ankles. The dermatological examination found erythematous papules, painful on palpation, indurated to the touch, on both buttocks.
As additional evidence, a blood test showed normocytic and normochromic anemia with a hematocrit of 27.7% (nv 36–45) and hemoglobin of 9.4g/dl (nv 12–16), together with a platelet count of 540,000 (nv 130–450). A search for iron deficiency showed (Fe: 18; vn 37–145) with normal ferritin, vitamin B12, folic acid and serum protein, and a peripheral blood smear which only highlighted a slight basophilia. The rest of the analytical studies only revealed subclinical hypothyroidism, with a slightly elevated TSH and normal thyroid hormones, for which we consulted the endocrinology department, which stated that the patient did not require replacement therapy. There was no leukocytosis or left shift, and renal and hepatic functions, ions and coagulation were normal. Acute phase reactants showed a sedimentation rate of 110mmHg and C-reactive protein 28.8mg/dl. Autoimmunity testing revealed rheumatoid factor of 24U/l, antinuclear antibodies 1/80, with negative anti neutrophil cytoplasmic antibodies. The angiotensin converting enzyme (ACE) was within normal values (ECA: 38; vn 18–58). Requested blood cultures were negative, and urine sediment was normal. Requested serology for hepatitis, human immunodeficiency virus, rubella, cytomegalovirus, Epstein–Barr virus, Toxoplasma, Treponema pallidum, Borrelia, Mycoplasma and Chlamydia were negative.
We performed a chest X-ray which displayed bilateral hilar lymphadenopathy (Fig. 2). To rule out a possible TB we performed a Mantoux test that was negative and serial urine auramines, which were also negative. We performed a high-resolution CT of the chest, which was compatible with grade I sarcoidosis (bilateral hilar and mediastinal lymphadenopathy) (Fig. 3). The transbronchial biopsy showed an inflammatory component in the bronchoalveolar lavage fluid and with a CD4/CD8 ratio of 5.26, with 80% of histiocytes, 15% lymphocytes and 5% neutrophils.
During admission we also found palpable and painful erythematous nodular lesions on the tibial region of both lower limbs (Fig. 4). After consulting with the dermatologist we performed a biopsy of the skin lesions of the buttocks and lower limbs. Pathology reported many histiocytes laden with lipid-containing cytoplasmic vacuoles affecting the septa and adipose tissue, which supported, given the clinical context, a diagnosis of factitious panniculitis due to silicone (Fig. 5). In contrast, biopsy of the skin over the pretibial showed a mixed, septal panniculitis with granulomas without necrosis, compatible with erythema nodosum with no evidence of silicone material (Fig. 6). The Ziehl-Neelsen and PAS stains were negative. She was treated with NSAIDs (indomethacin 50mg/8h), with very good clinical response, remaining afebrile, with a decrease in swelling of the ankle and progressive disappearance of skin lesions.
Subsequently, visits to the departments of rheumatology, dermatology and respiratory medicine found the patient to be asymptomatic. No new outbreaks were seen even though she has not removed the silicone implants.
DiscussionSarcoidosis is a systemic granulomatous disease of unknown etiology that affects mainly young people, and whose most frequent clinical manifestations are bilateral hilar lymphadenopathy, pulmonary infiltrates and skin and eye lesions.9 It is characterized by the formation of noncaseating granulomas.
Löfgren in 1946 first described a syndrome characterized by the association of erythema nodosum and bilateral hilar lymphadenopathy. This syndrome is a form of acute or subacute sarcoidosis, usually benign in nature, often accompanied by polyarthritis/polyarticular joint pain and fever, and that is spontaneously resolved.9 It is usually associated with HLA-DRB1*03.
The pathogenesis of sarcoidosis is mediated by T cell dysfunction and hyperactivity of B cells, resulting from an abnormal immune response against a variety of specific environmental agents, which act as antigens and affect genetically predisposed individuals. Experiments with rats have shown that silicone is able to activate the humoral response and lead to delayed hypersensitivity and also exerts a direct effect on macrophages, causing the release of cytokines, with subsequent activation of lymphocytes.4 Thus, it is believed that in a predisposed individual, silicone may act as the triggering antigen leading to the aberrant immune responses and many systemic manifestations.4 A wide variety of connective tissue diseases (systemic sclerosis, lupus erythematosus, rheumatoid arthritis) have been associated with silicone2 implants. Specifically, several papers3,5–8 refer to the appearance of sarcoidosis or Löfgren syndrome in previously healthy people, as in our case, after undergoing various surgical procedures, mainly cosmetic, and silicone made implants in various body areas. Manifestations were particularly severe in some of these patients, with very marked constitutional symptoms characterized by fever, generalized joint pain, fatigue, intense lymphadenopathy and skin lesions, as well as moderate pleural effusion.3,4,7,8 In all cases a chest radiograph and chest CT were performed, and a biopsy taken from the lymph nodes or skin lesions, showing noncaseating granulomas and ruling out TB by staining with Zhiel Nielsen. In most patients it was necessary, in addition to treatment with systemic corticosteroids, to remove the silicone implants, although one case was spared.7
On the other hand, silicone injections can cause foreign body reactions of the skin, which may extend to subcutaneous fat tissue, causing a factitial panniculitis.1 Lesions usually appear months or years after the injection as erythematous nodules or plaques, tender to palpation, even sometimes leading to ulcers and fatty necrosis.10 Histology is characteristic and consists of a lobular panniculitis with giant multinucleated cells as a foreign body reaction. Material is frequently found within the vacuoles, which in this case consists of lipids or oil.10 The presence of vacuoles of various sizes can produce the typical “Swiss cheese” appearance.
The etiological treatment (removal of the injected product) can be difficult, especially when it comes to liquid silicone. For symptomatic treatment local corticosteroids are used, systemically, mynocyclin11 and imiquimod 5%.
An increase in the percentage of NK cells and neutrophils in bronchoalveolar lavage fluid is associated with a poor prognosis and the likelihood of increased requirement for steroids, contrary to what happened with our patient, which may have contributed to rapid improvement, even without steroids or removing the material.
ConclusionsSilicone is a material frequently used in plastic surgery and, as noted, may produce undesirable reactions both locally and systemically. The highlight of the event here exposed is that the patient had, on the one hand, a local reaction in the form of factitious panniculitis (buttocks skin biopsy where we found large numbers of cytoplasmic vacuole-laden histiocytes filled with a lipid material compatible with silicone) and, second, Löfgren's syndrome with fever, arthralgias, hilar lymphadenopathy and skin lesions such as erythema nodosum (pretibial area skin biopsy showing a mixed septal panniculitis, without evidence of lipid droplets to suggest silicone implants). Unlike other cases reported in other scientific publications, it was not necessary at present to remove the silicone or use systemic corticosteroid, as the patient responded favorably to the use of NSAIDS.
Ethical disclosuresProtection of human and animal subjects. The authors declare that no experiments were performed on humans or animals for this investigation.
Confidentiality of Data. The authors declare that they have followed the protocols of their work centre on the publication of patient data and that all the patients included in the study have received sufficient information and have given their informed consent in writing to participate in that study.
Right to privacy and informed consent. The authors have obtained the informed consent of the patients and /or subjects mentioned in the article. The author for correspondence is in possession of this document.
Conflict of InterestThe authors declare no conflict of interest.
Please cite this article as: Diez Morrondo C, et al. Paniculitis facticia y síndrome de Löfgren inducidos por silicona: a propósito de un caso clínico. Reumatol Clin. 2012;8:368–71.